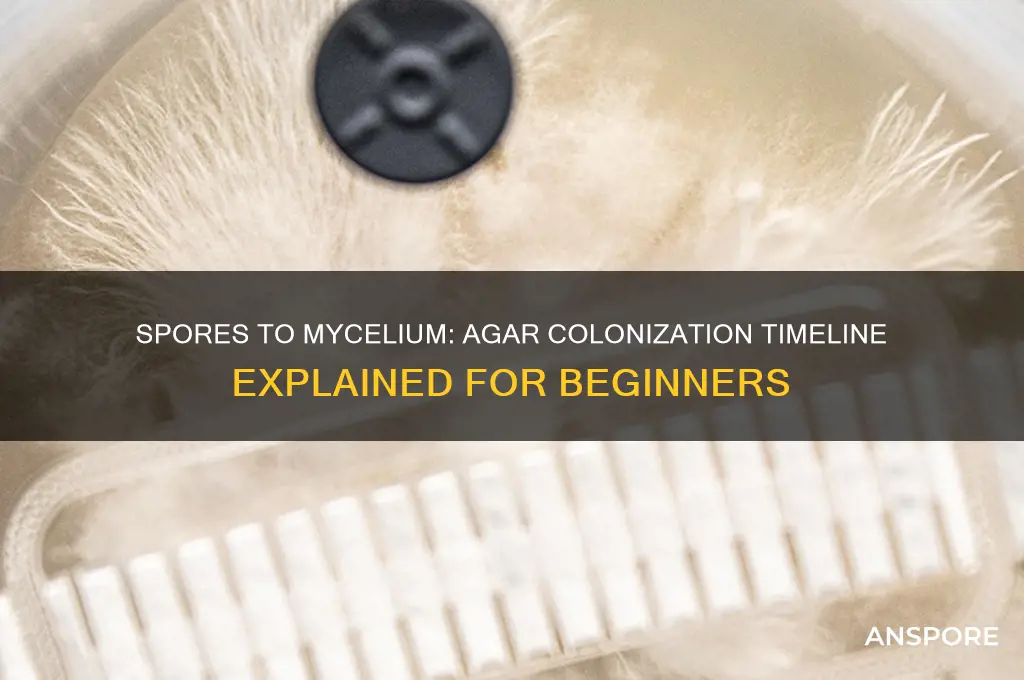
how long spores to mycelium agar

The process of transforming spores into mycelium on agar is a fascinating aspect of mycology, requiring patience and precision. Spores, the microscopic reproductive units of fungi, are inoculated onto a nutrient-rich agar medium, where they germinate under optimal conditions of temperature, humidity, and sterility. The time it takes for spores to develop into visible mycelium varies widely, typically ranging from 7 to 21 days, depending on the fungal species, environmental factors, and the quality of the agar. This critical phase is crucial for cultivating fungi, whether for research, culinary purposes, or medicinal applications, as it lays the foundation for healthy and robust mycelial growth. Understanding this timeline and the factors influencing it is essential for successful fungal cultivation.
| Characteristics | Values |
|---|---|
| Time for Spores to Germinate | Typically 3–7 days, depending on species and conditions |
| Optimal Temperature for Germination | 22–28°C (72–82°F) |
| Agar Medium Requirements | Nutrient-rich agar (e.g., malt extract agar, potato dextrose agar) |
| Humidity Needed | High humidity (near 100%) for successful germination |
| Light Requirements | Indirect light or darkness is acceptable |
| Species Variability | Time can vary widely between mushroom species (e.g., oyster vs. shiitake) |
| Contamination Risk | High during initial stages; sterile techniques are crucial |
| Visible Mycelium Growth | Appears as white, fuzzy patches after 7–14 days post-germination |
| pH Range for Optimal Growth | 5.5–6.5 |
| Common Challenges | Contamination, improper sterilization, or incorrect environmental conditions |
Explore related products
What You'll Learn
- Optimal Temperature Range: Ideal temperatures for spore germination and mycelium growth on agar
- Sterilization Techniques: Methods to ensure agar and tools are free from contaminants
- Spore Viability Testing: Assessing spore health before inoculation for successful mycelium development
- Agar Preparation Steps: Detailed process for preparing nutrient-rich agar for mycelium cultivation
- Timeframe for Colonization: Expected duration for spores to fully colonize agar plates

Optimal Temperature Range: Ideal temperatures for spore germination and mycelium growth on agar
Temperature is the linchpin for transforming spores into mycelium on agar. The process demands precision, as even slight deviations can stall germination or foster contamination. Ideal temperatures for spore germination typically range between 22°C to 28°C (72°F to 82°F), mirroring the conditions fungi encounter in their natural habitats. This range activates enzymes essential for breaking down the spore wall, initiating growth. However, once mycelium emerges, slightly cooler temperatures—around 20°C to 24°C (68°F to 75°F)—often optimize expansion while minimizing stress on the colony.
Consider the incubation environment as a controlled ecosystem. Fluctuations outside the optimal range can disrupt metabolic processes. For instance, temperatures above 30°C (86°F) may denature proteins, halting growth, while temperatures below 18°C (64°F) slow enzymatic activity to a crawl. Consistency is key; use a thermostat-controlled incubator or a heating pad with a thermometer to maintain stability. For hobbyists without specialized equipment, placing agar plates in a dark, warm location like a closed cabinet near a heat source can suffice, provided the temperature remains within the target range.
Comparing species reveals nuanced temperature preferences. Tropical fungi, such as *Trametes versicolor*, thrive at the higher end of the spectrum, whereas temperate species like *Pleurotus ostreatus* prefer the lower range. Understanding these preferences accelerates colonization. For example, inoculating *Psilocybe cubensis* spores at 26°C (79°F) often yields visible mycelium within 7–10 days, while cooler-adapted species may take 14–21 days under the same conditions. Always research the specific fungus to tailor the environment for success.
Practical tips can enhance temperature control. Pre-warming agar plates to room temperature before inoculation prevents thermal shock to spores. Avoid direct heat sources, as they can create hotspots that damage delicate mycelium. For long-term storage of colonized agar, reduce the temperature to 4°C (39°F) to slow growth and preserve viability without inducing dormancy. Monitoring humidity alongside temperature is equally critical, as dry air can desiccate agar, impeding growth even within the ideal thermal range.
In conclusion, mastering temperature control is both art and science. By adhering to species-specific ranges and maintaining consistency, cultivators can reliably predict the timeline from spore to mycelium. This precision not only accelerates growth but also safeguards against contamination, ensuring a robust foundation for further cultivation. Whether using advanced equipment or improvising with household items, the goal remains the same: create a stable, optimal environment for fungal life to flourish.
Spore-Forming Bacteria: Gram-Positive or Gram-Negative Classification Explained
You may want to see also

Sterilization Techniques: Methods to ensure agar and tools are free from contaminants
Sterilization is the cornerstone of successful mycelium cultivation, ensuring that agar and tools remain uncontaminated throughout the process. Without proper sterilization, even the most meticulously prepared agar can become a breeding ground for unwanted microorganisms, jeopardizing the growth of mycelium from spores. The goal is to eliminate all viable microbes, including bacteria, fungi, and their spores, through methods that are both effective and practical for home or laboratory settings.
Autoclaving: The Gold Standard
The autoclave is the most reliable sterilization method, using steam under pressure to achieve temperatures of 121°C (250°F) for 15–30 minutes. This process is ideal for sterilizing agar, Petri dishes, and metal tools. For agar preparation, dissolve the agar in water, dispense it into containers, and seal them loosely before autoclaving. Ensure the autoclave reaches 15 psi to guarantee thorough sterilization. Caution: Always allow the autoclave to cool naturally to avoid contamination from airborne particles when opening.
Chemical Sterilization: A Practical Alternative
When an autoclave is unavailable, chemical sterilization offers a viable solution. Ethanol (70%) and isopropyl alcohol (90%) are effective for sterilizing surfaces and small tools. Submerge tools in alcohol for 10–15 minutes, then allow them to air-dry in a sterile environment. For agar, filter-sterilize using a 0.22-micron filter to remove contaminants without heat. This method is particularly useful for heat-sensitive materials but may not eliminate all spore forms.
Flame Sterilization: Quick and Precise
Flame sterilization is ideal for small tools like inoculation loops and needles. Pass the tool through a bunsen burner flame until it glows red-hot, ensuring all surfaces are exposed. This method is immediate but requires caution to avoid burns or melting of plastic components. Pair flame sterilization with a sterile workspace to minimize recontamination risks.
Comparative Analysis and Practical Tips
While autoclaving is the most thorough method, it requires specialized equipment. Chemical sterilization is accessible but less reliable for spores. Flame sterilization is quick but limited in scope. For home cultivators, combining methods—such as autoclaving agar and flame-sterilizing tools—maximizes success. Always work in a clean environment, use sterile gloves, and minimize exposure to air during transfers. Regularly inspect tools and agar for signs of contamination, such as discoloration or unusual odors, to catch issues early.
By mastering these sterilization techniques, cultivators can create a contaminant-free environment, ensuring spores develop into healthy mycelium on agar with minimal interference. Precision and consistency in sterilization practices are key to achieving reliable results in mycology.
Ionizers and Mold: Can They Effectively Kill Spores in Your Home?
You may want to see also

Spore Viability Testing: Assessing spore health before inoculation for successful mycelium development
Spores are the starting point for mycelium cultivation, but not all spores are created equal. Viability testing is crucial to ensure successful colonization of agar plates, as dormant or damaged spores can lead to failed inoculations. This process involves assessing spore health through germination tests, which provide insights into their potential to develop into mycelium. By evaluating viability, cultivators can select the most robust spores, increasing the likelihood of a thriving mycelial network.
One common method for spore viability testing is the agar plate germination assay. To perform this test, prepare a sterile agar medium, such as potato dextrose agar (PDA), and inoculate it with a known quantity of spores—typically 100–200 spores per plate. Incubate the plates at an optimal temperature, usually 22–28°C, for 24–48 hours. Healthy spores should germinate within this timeframe, producing visible hyphae. Counting the number of germinated spores relative to the total provides a germination rate, with rates above 70% considered acceptable for inoculation.
Another approach is the tetrazolium assay, which relies on a redox indicator to assess metabolic activity in spores. Mix a small spore sample with a 0.5% tetrazolium solution and incubate for 1–2 hours. Viable spores reduce the tetrazolium salt, producing a red color, while non-viable spores remain unstained. This method offers a quick assessment but may not always correlate perfectly with germination potential. Combining it with the agar plate assay provides a more comprehensive evaluation.
For cultivators working with aged or stored spores, viability testing becomes even more critical. Spores can lose viability over time, particularly if stored improperly. Exposure to moisture, extreme temperatures, or prolonged storage beyond 2 years can significantly reduce germination rates. Before inoculating agar plates, test stored spores to confirm their health, discarding batches with viability below 50%. This precautionary step prevents wasted resources and time.
Incorporating spore viability testing into the cultivation workflow ensures a higher success rate in mycelium development. By selecting only the healthiest spores, cultivators can minimize the risk of contamination and failed cultures. While the process requires additional time and materials, the long-term benefits of robust mycelial growth far outweigh the initial investment. Whether using agar plate assays, tetrazolium tests, or a combination of both, this practice is indispensable for achieving consistent and reliable results in mycology.
Do Moss Capsules Contain Spores? Unveiling the Mystery of Bryophyte Reproduction
You may want to see also
Explore related products

Agar Preparation Steps: Detailed process for preparing nutrient-rich agar for mycelium cultivation
The transformation of spores into mycelium on agar is a delicate dance of nutrients, sterility, and patience. While the time frame varies depending on species and conditions, understanding the agar preparation process is crucial for success. This nutrient-rich foundation dictates the health and vigor of your mycelium, ultimately influencing yield and potency.
Let's delve into the meticulous steps of crafting the ideal agar medium.
Precise Measurement and Sterilization: Begin by gathering your ingredients: agar powder (typically 15-20 grams per liter of water), a suitable carbohydrate source like malt extract or dextrose (10-20 grams), and optional additives like vitamins or minerals. Precision is paramount; use a digital scale for accurate measurements. Combine the dry ingredients in a sterile container, then slowly add distilled water, stirring constantly to prevent lumps. Heat the mixture to a gentle boil, ensuring complete dissolution. Autoclaving at 121°C for 15-20 minutes is essential to eliminate contaminants. This step, though time-consuming, is non-negotiable for successful mycelium cultivation.
Pouring and Cooling: A Balancing Act: Once sterilized, allow the agar solution to cool slightly, aiming for a temperature range of 50-60°C. This prevents the Petri dishes from cracking and ensures even distribution. Work in a sterile environment, ideally a laminar flow hood, to minimize airborne contaminants. Pour the agar into Petri dishes, filling them approximately three-quarters full. Allow the agar to solidify at room temperature, a process that typically takes 30-60 minutes. Avoid rushing this step, as improper cooling can lead to uneven surfaces and compromised results.
Inoculation and Incubation: Patience Rewarded: With your agar plates solidified and cooled, it's time for inoculation. Using a sterile inoculation loop or needle, carefully transfer a small amount of spore solution onto the agar surface. Gently spread the spores across the agar, ensuring even distribution. Incubate the plates in a dark, warm environment (22-28°C) for 7-14 days. During this period, the spores will germinate, sending out delicate strands of mycelium. Resist the urge to disturb the plates during this critical phase, as even minor disruptions can hinder growth.
The journey from spore to mycelium on agar is a testament to the resilience and complexity of fungi. By meticulously preparing nutrient-rich agar and providing optimal conditions, you create a nurturing environment for these remarkable organisms to thrive. Remember, patience and attention to detail are key to unlocking the full potential of your mycelium cultivation endeavors.
Spore Syringe Colonization Timeline: Factors Affecting Growth and Duration
You may want to see also

Timeframe for Colonization: Expected duration for spores to fully colonize agar plates
Spores, when introduced to agar plates, undergo a transformation into mycelium, but the timeline for this process varies significantly. Typically, the initial signs of germination appear within 3 to 7 days, depending on factors like spore viability, agar nutrient composition, and environmental conditions. However, full colonization of the agar plate—where mycelium covers the entire surface—usually takes 2 to 4 weeks. This duration is critical for researchers and cultivators, as it determines the next steps in experimentation or cultivation.
Analyzing the variables, temperature plays a pivotal role in accelerating or delaying colonization. Optimal temperatures range between 22°C to 28°C (72°F to 82°F), with deviations slowing growth. For instance, cooler temperatures may extend the colonization period to 6 weeks, while warmer conditions can reduce it to 10–14 days if not overheating. Humidity and sterility are equally crucial; contamination can halt progress entirely, while low humidity may desiccate the agar, stunting growth.
Instructively, to expedite colonization, ensure spores are evenly distributed across the agar surface using a sterile technique. A common method involves diluting spore solution with sterile water (1:10 ratio) and applying 1–2 mL per plate. After inoculation, seal plates with parafilm or micropore tape to maintain humidity while allowing gas exchange. Regularly inspect plates under a sterile hood to monitor progress and detect contamination early.
Comparatively, the colonization timeframe on agar is significantly shorter than on substrates like grain or wood, where mycelium can take 6 to 12 weeks to fully colonize. This disparity highlights agar’s efficiency as a medium for rapid mycelial growth, making it ideal for research, strain isolation, and genetic studies. However, agar’s cost and limited scalability often relegate it to preliminary stages before transitioning to bulk substrates.
Practically, patience is key. While the urge to manipulate plates may arise, disturbances increase contamination risk. Instead, maintain a consistent environment and document growth daily for accurate tracking. For advanced users, incorporating supplements like vitamins (B12, thiamine) or growth hormones (e.g., gibberellic acid at 0.1–1 mg/L) can reduce colonization time by 20–30%, though these additions require precise calibration to avoid inhibiting growth.
Do Clorox Wipes Effectively Kill Bacterial Spores? A Deep Dive
You may want to see also
Frequently asked questions
It usually takes 7 to 14 days for spores to germinate and form visible mycelium on agar, depending on the species and environmental conditions.
Factors include temperature, humidity, agar nutrient composition, spore viability, and sterility of the environment. Optimal conditions accelerate growth.
Yes, maintaining ideal conditions such as a temperature of 22–28°C (72–82°F) and using high-quality spores can reduce the time to as little as 5–7 days.
Check for contamination, ensure proper incubation conditions, and verify spore viability. If issues persist, start with fresh spores or agar plates.

























